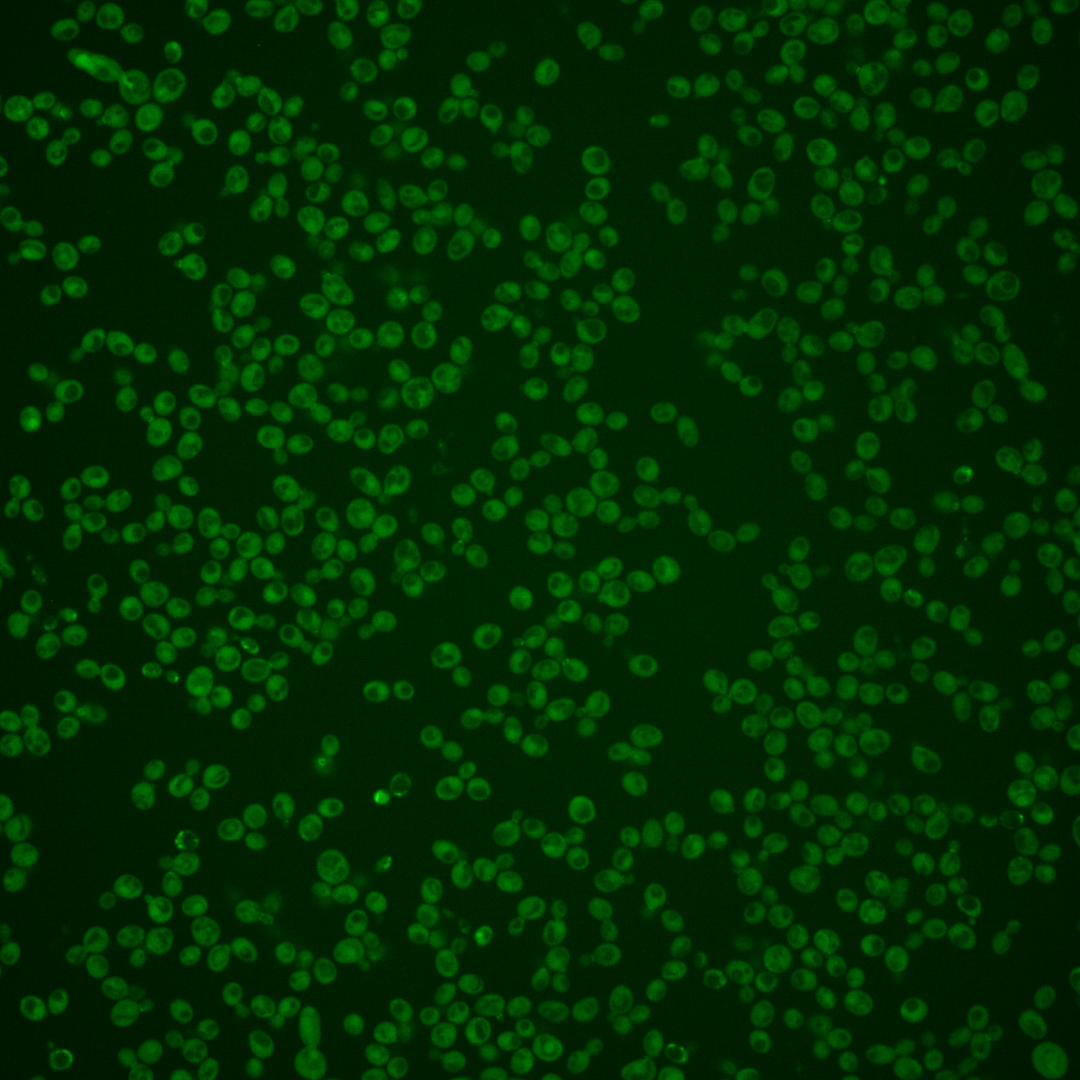
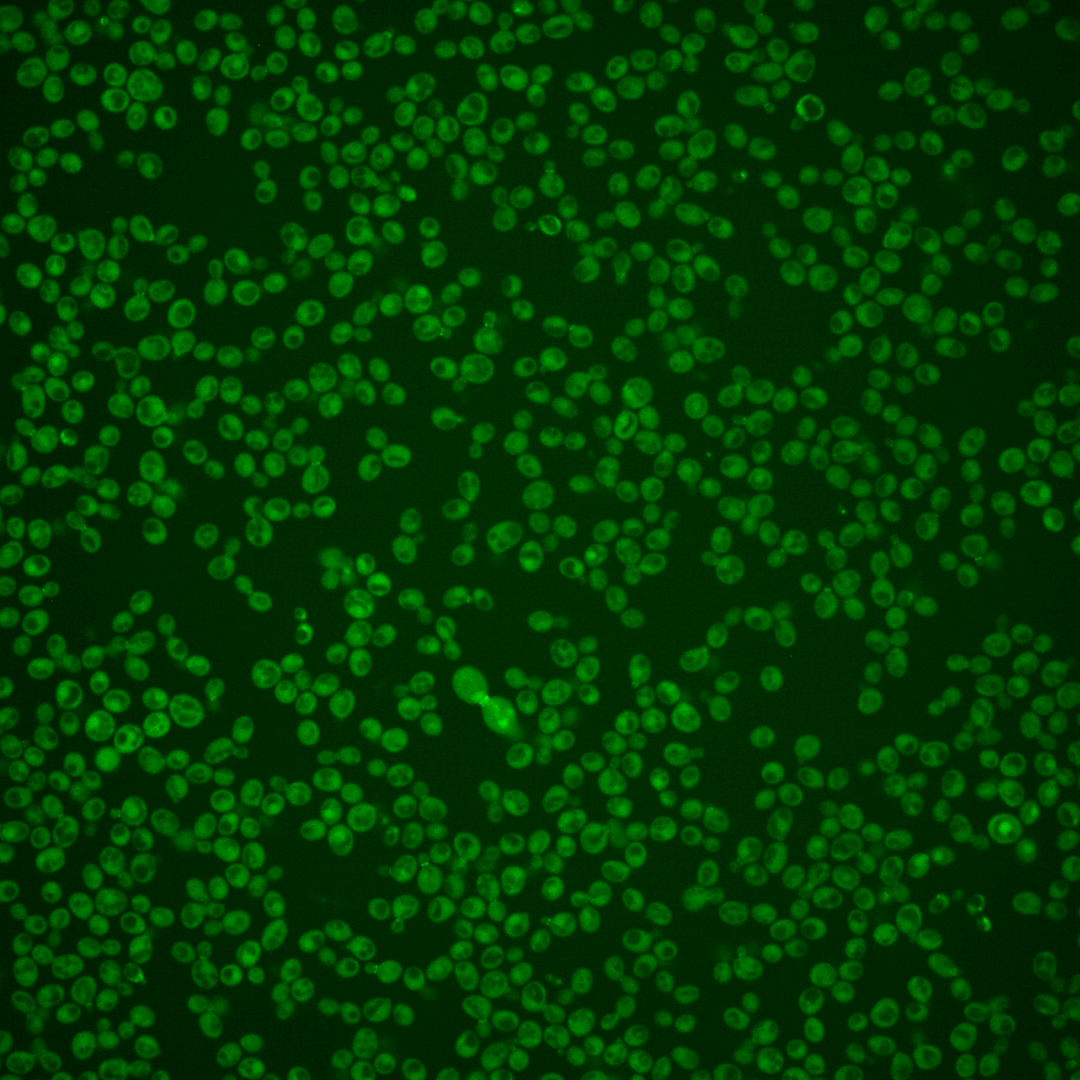
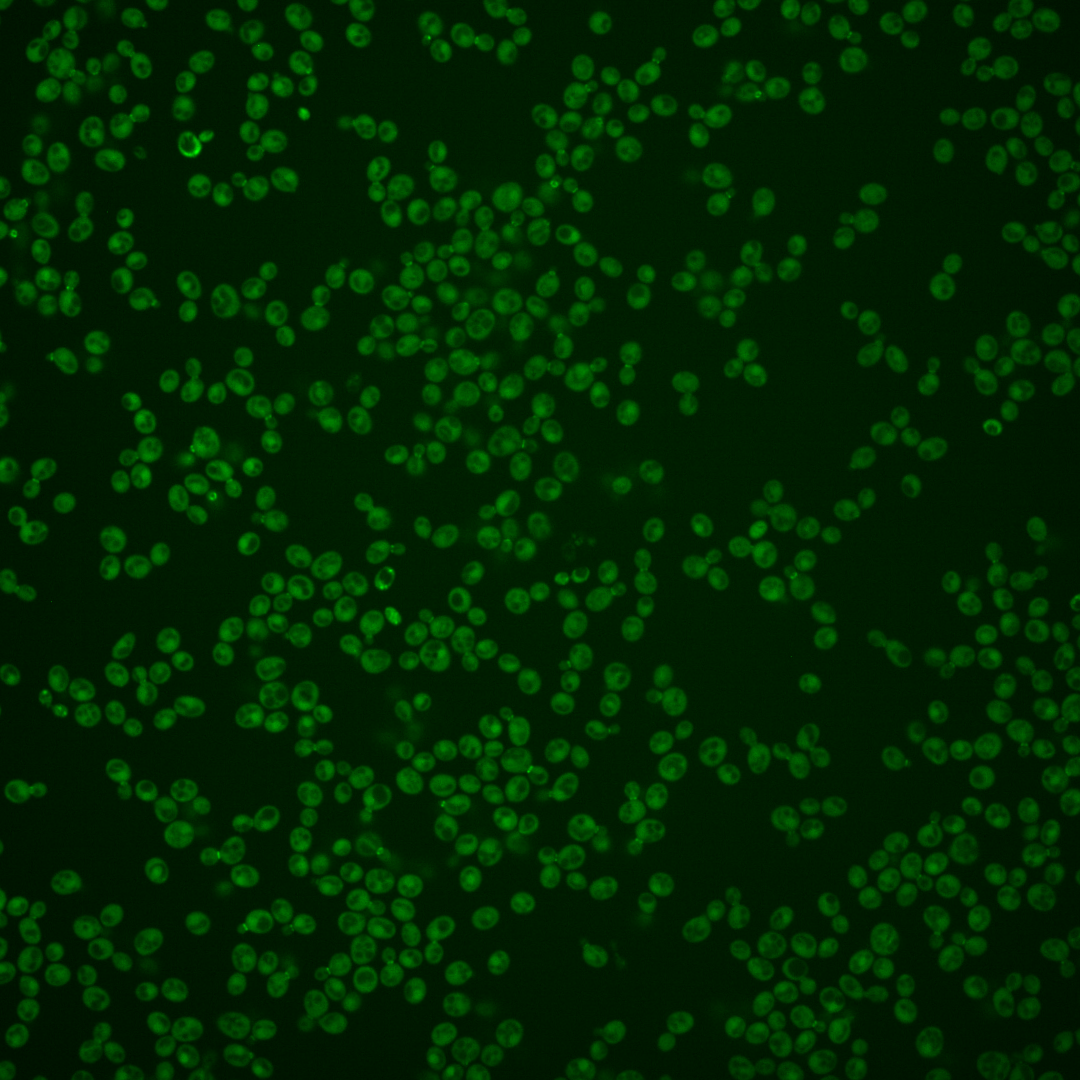
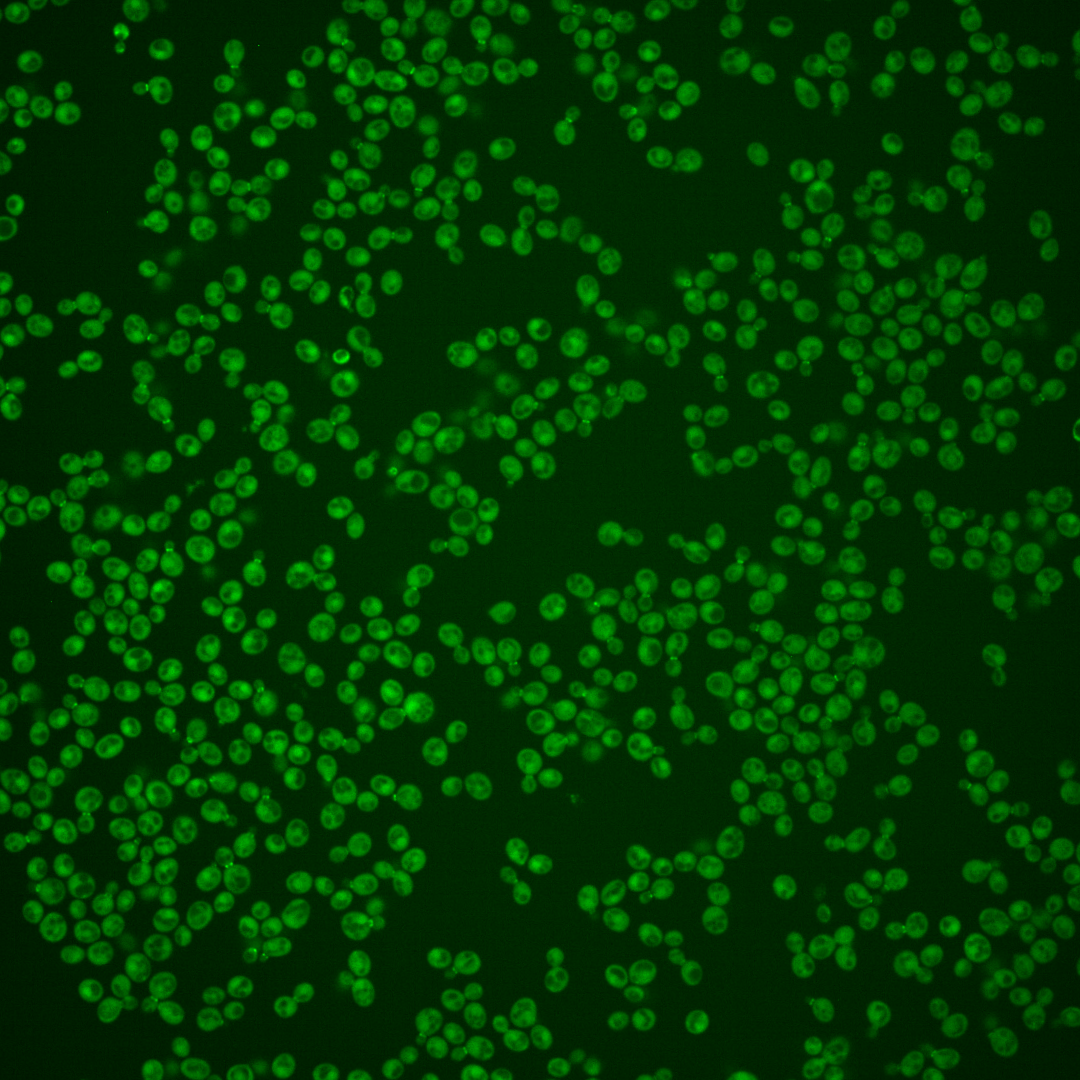

| Standard name | |
|---|---|
| Human Ortholog | |
| Description | Protein arginine N-methyltransferase; exhibits septin and Hsl1p-dependent localization to the bud neck in budded cells and periodic Hsl1p-dependent phosphorylation; required with Hsl1p, and Elm1p for the mother-bud neck recruitment, phosphorylation, and degradation of Swe1p; interacts directly with Swe1p; relocalizes away from bud neck upon DNA replication stress; human homolog PRMT5 can complement yeast hsl7 mutant |
Micrographs




















































































Sub-cellular Localization
Yeast GFP Assignment
Protein Abundance
Localization Change
External localization resources
| ensLOC | DeepLoc | |||||||||||||||||||||||
|---|---|---|---|---|---|---|---|---|---|---|---|---|---|---|---|---|---|---|---|---|---|---|---|---|
| Localization | WT1 | WT2 | WT3 | RAP60 | RAP140 | RAP220 | RAP300 | RAP380 | RAP460 | RAP540 | RAP620 | RAP700 | HU80 | HU120 | HU160 | rpd3Δ_1 | rpd3Δ_2 | rpd3Δ_3 | WT1 | WT2 | WT3 | AF100 | AF140 | AF180 |
| Cortical Patches | 8 | 16 | 1 | 1 | 7 | 0 | 3 | 2 | 5 | 0 | 0 | 4 | 2 | 4 | 2 | 5 | 6 | 1 | 10 | 24 | 3 | 1 | 3 | 5 |
| Bud | 6 | 27 | 2 | 7 | 11 | 11 | 9 | 12 | 21 | 14 | 17 | 18 | 12 | 7 | 5 | 1 | 1 | 0 | 7 | 14 | 2 | 0 | 5 | 5 |
| Bud Neck | 2 | 1 | 3 | 4 | 4 | 6 | 4 | 11 | 7 | 2 | 5 | 5 | 0 | 0 | 0 | 0 | 1 | 0 | 25 | 46 | 8 | 2 | 2 | 1 |
| Bud Site | 0 | 1 | 0 | 0 | 0 | 0 | 0 | 2 | 4 | 7 | 2 | 5 | 0 | 0 | 0 | 0 | 0 | 0 | – | – | – | – | – | – |
| Cell Periphery | 3 | 2 | 5 | 2 | 2 | 3 | 3 | 2 | 1 | 0 | 0 | 0 | 1 | 2 | 0 | 9 | 5 | 2 | 0 | 0 | 0 | 0 | 0 | 0 |
| Cytoplasm | 120 | 482 | 182 | 143 | 152 | 120 | 149 | 162 | 102 | 107 | 112 | 107 | 244 | 489 | 505 | 85 | 77 | 47 | 97 | 408 | 146 | 262 | 391 | 379 |
| Endoplasmic Reticulum | 7 | 6 | 1 | 0 | 0 | 0 | 0 | 0 | 0 | 0 | 0 | 0 | 1 | 2 | 2 | 8 | 3 | 3 | 0 | 2 | 4 | 2 | 8 | 10 |
| Endosome | 2 | 9 | 0 | 2 | 3 | 1 | 6 | 1 | 0 | 0 | 2 | 0 | 6 | 19 | 8 | 4 | 4 | 0 | 6 | 26 | 2 | 1 | 1 | 2 |
| Golgi | 0 | 1 | 0 | 0 | 0 | 0 | 0 | 0 | 0 | 0 | 0 | 0 | 0 | 0 | 0 | 1 | 3 | 0 | 0 | 2 | 1 | 0 | 0 | 1 |
| Mitochondria | 0 | 5 | 1 | 4 | 4 | 16 | 36 | 17 | 51 | 71 | 67 | 57 | 1 | 0 | 0 | 1 | 2 | 1 | 0 | 8 | 5 | 7 | 6 | 4 |
| Nucleus | 0 | 7 | 1 | 2 | 0 | 1 | 3 | 4 | 2 | 5 | 0 | 2 | 0 | 0 | 1 | 0 | 0 | 1 | 0 | 3 | 3 | 0 | 1 | 3 |
| Nuclear Periphery | 0 | 0 | 0 | 0 | 0 | 0 | 0 | 0 | 0 | 0 | 1 | 1 | 1 | 1 | 0 | 1 | 0 | 0 | 0 | 0 | 0 | 0 | 0 | 0 |
| Nucleolus | 0 | 0 | 0 | 0 | 0 | 0 | 1 | 2 | 0 | 0 | 0 | 1 | 0 | 1 | 1 | 1 | 1 | 0 | 0 | 0 | 0 | 0 | 0 | 0 |
| Peroxisomes | 1 | 1 | 0 | 0 | 2 | 0 | 1 | 2 | 2 | 1 | 3 | 1 | 1 | 3 | 0 | 0 | 0 | 0 | 1 | 1 | 0 | 0 | 0 | 0 |
| SpindlePole | 1 | 2 | 2 | 8 | 14 | 5 | 19 | 13 | 13 | 7 | 3 | 15 | 0 | 2 | 0 | 1 | 0 | 0 | 3 | 8 | 0 | 0 | 2 | 0 |
| Vac/Vac Membrane | 2 | 7 | 3 | 3 | 1 | 1 | 2 | 7 | 1 | 1 | 3 | 2 | 2 | 7 | 3 | 3 | 3 | 2 | 0 | 15 | 6 | 7 | 13 | 19 |
| Unique Cell Count | 142 | 531 | 191 | 164 | 186 | 146 | 193 | 206 | 161 | 171 | 163 | 165 | 259 | 525 | 518 | 97 | 93 | 51 | 156 | 569 | 191 | 289 | 443 | 442 |
| Labelled Cell Count | 152 | 567 | 201 | 176 | 200 | 164 | 236 | 237 | 209 | 215 | 215 | 218 | 271 | 537 | 527 | 120 | 106 | 57 | 156 | 569 | 191 | 289 | 443 | 442 |
Yeast GFP Assignment
Protein Abundance
| Screen | WT1 | WT2 | WT3 | RAP60 | RAP140 | RAP220 | RAP300 | RAP380 | RAP460 | RAP540 | RAP620 | RAP700 | HU80 | HU120 | HU160 | rpd3Δ_1 | rpd3Δ_2 | rpd3Δ_3 | AF100 | AF140 | AF180 |
|---|---|---|---|---|---|---|---|---|---|---|---|---|---|---|---|---|---|---|---|---|---|
| Mean Cell GFP Intensity (1e-4) | 6.0 | 5.6 | 6.2 | 5.6 | 5.8 | 4.8 | 5.1 | 5.4 | 4.0 | 3.9 | 3.7 | 4.4 | 5.6 | 5.9 | 5.9 | 8.8 | 9.2 | 7.4 | 5.4 | 5.8 | 6.3 |
| Std Deviation (1e-4) | 1.4 | 0.7 | 1.9 | 1.7 | 1.4 | 1.6 | 1.9 | 2.0 | 1.0 | 1.3 | 0.9 | 1.4 | 1.0 | 0.9 | 1.0 | 1.7 | 2.2 | 0.9 | 0.9 | 1.0 | 1.1 |
| Intensity Change (Log2) | – | – | – | -0.15 | -0.11 | -0.37 | -0.29 | -0.21 | -0.65 | -0.66 | -0.74 | -0.51 | -0.15 | -0.09 | -0.08 | 0.5 | 0.57 | 0.26 | -0.21 | -0.09 | 0.01 |
Localization Change
| Localization | RAP60 | RAP140 | RAP220 | RAP300 | RAP380 | RAP460 | RAP540 | RAP620 | RAP700 | HU80 | HU120 | HU160 | rpd3Δ_1 | rpd3Δ_2 | rpd3Δ_3 |
|---|---|---|---|---|---|---|---|---|---|---|---|---|---|---|---|
| Cortical Patches | 0 | 0 | 0 | 0 | 0 | 0 | 0 | 0 | 0 | 0 | 0 | 0 | 0 | 0 | 0 |
| Bud | 0 | 2.6 | 0 | 2.1 | 2.6 | 0 | 0 | 0 | 0 | 2.2 | 0 | 0 | 0 | 0 | 0 |
| Bud Neck | 0 | 0 | 0 | 0 | 2.0 | 0 | 0 | 0 | 0 | 0 | 0 | 0 | 0 | 0 | 0 |
| Bud Site | 0 | 0 | 0 | 0 | 0 | 0 | 0 | 0 | 0 | 0 | 0 | 0 | 0 | 0 | 0 |
| Cell Periphery | 0 | 0 | 0 | 0 | 0 | 0 | 0 | 0 | 0 | 0 | 0 | 0 | 0 | 0 | 0 |
| Cytoplasm | -2.7 | -4.1 | -3.9 | -5.1 | -4.9 | -7.6 | -7.7 | -6.6 | -7.3 | -0.5 | -1.0 | 1.5 | -2.4 | -3.5 | -0.9 |
| Endoplasmic Reticulum | 0 | 0 | 0 | 0 | 0 | 0 | 0 | 0 | 0 | 0 | 0 | 0 | 0 | 0 | 0 |
| Endosome | 0 | 0 | 0 | 0 | 0 | 0 | 0 | 0 | 0 | 0 | 2.7 | 0 | 0 | 0 | 0 |
| Golgi | 0 | 0 | 0 | 0 | 0 | 0 | 0 | 0 | 0 | 0 | 0 | 0 | 0 | 0 | 0 |
| Mitochondria | 0 | 0 | 0 | 6.0 | 3.7 | 0 | 0 | 0 | 0 | 0 | 0 | 0 | 0 | 0 | 0 |
| Nucleus | 0 | 0 | 0 | 0 | 0 | 0 | 0 | 0 | 0 | 0 | 0 | 0 | 0 | 0 | 0 |
| Nuclear Periphery | 0 | 0 | 0 | 0 | 0 | 0 | 0 | 0 | 0 | 0 | 0 | 0 | 0 | 0 | 0 |
| Nucleolus | 0 | 0 | 0 | 0 | 0 | 0 | 0 | 0 | 0 | 0 | 0 | 0 | 0 | 0 | 0 |
| Peroxisomes | 0 | 0 | 0 | 0 | 0 | 0 | 0 | 0 | 0 | 0 | 0 | 0 | 0 | 0 | 0 |
| SpindlePole | 0 | 3.1 | 0 | 3.8 | 2.7 | 0 | 0 | 0 | 0 | 0 | 0 | 0 | 0 | 0 | 0 |
| Vacuole | 0 | 0 | 0 | 0 | 0 | 0 | 0 | 0 | 0 | 0 | 0 | 0 | 0 | 0 | 0 |
External localization resources
Images






























Protein Concentration and Protein Localization Data
| R1 | R2 | R3 | ||||||||||||||||
|---|---|---|---|---|---|---|---|---|---|---|---|---|---|---|---|---|---|---|
| G1 Pre-START | G1 Post-START | S/G2 | Metaphase | Anaphase | Telophase | G1 Pre-START | G1 Post-START | S/G2 | Metaphase | Anaphase | Telophase | G1 Pre-START | G1 Post-START | S/G2 | Metaphase | Anaphase | Telophase | |
| Concentration | 3.2431 | 3.6255 | 3.2719 | 2.8378 | 3.2229 | 3.6099 | 1.2616 | 2.0337 | 1.6782 | 1.6558 | 1.5839 | 1.5414 | 0.7328 | 1.5867 | 0.9014 | 1.1917 | 0.9469 | 1.0385 |
| Actin | 0.0585 | 0.0027 | 0.038 | 0.0114 | 0.037 | 0.0342 | 0.0496 | 0.0124 | 0.0314 | 0.0332 | 0.0205 | 0.0153 | 0.0805 | 0.0054 | 0.0172 | 0.033 | 0.0084 | 0.0244 |
| Bud | 0.0045 | 0.003 | 0.0015 | 0.0017 | 0.0021 | 0.0005 | 0.011 | 0.0042 | 0.0072 | 0.0092 | 0.0187 | 0.0019 | 0.0043 | 0.0021 | 0.0014 | 0.0006 | 0.0018 | 0.0012 |
| Bud Neck | 0.0057 | 0.0184 | 0.5221 | 0.69 | 0.6203 | 0.2025 | 0.0299 | 0.0177 | 0.4534 | 0.6147 | 0.5114 | 0.166 | 0.0424 | 0.0414 | 0.4705 | 0.695 | 0.5833 | 0.194 |
| Bud Periphery | 0.0052 | 0.0014 | 0.0018 | 0.0021 | 0.0041 | 0.0008 | 0.0134 | 0.0046 | 0.0093 | 0.0256 | 0.0186 | 0.0044 | 0.0037 | 0.0013 | 0.0014 | 0.0006 | 0.0019 | 0.0014 |
| Bud Site | 0.0448 | 0.1562 | 0.1866 | 0.0235 | 0.009 | 0.0017 | 0.104 | 0.227 | 0.1823 | 0.014 | 0.0362 | 0.0038 | 0.1496 | 0.0808 | 0.163 | 0.0202 | 0.0237 | 0.0077 |
| Cell Periphery | 0.003 | 0.0014 | 0.0026 | 0.0027 | 0.0015 | 0.0006 | 0.001 | 0.0009 | 0.001 | 0.0004 | 0.0017 | 0.0001 | 0.0009 | 0.001 | 0.0008 | 0.0005 | 0.0004 | 0.0002 |
| Cytoplasm | 0.3948 | 0.5303 | 0.1173 | 0.0497 | 0.2151 | 0.5139 | 0.4443 | 0.5601 | 0.1615 | 0.0946 | 0.1069 | 0.6644 | 0.4222 | 0.6235 | 0.1353 | 0.13 | 0.1523 | 0.6152 |
| Cytoplasmic Foci | 0.0867 | 0.0381 | 0.0406 | 0.0398 | 0.088 | 0.0513 | 0.0901 | 0.0394 | 0.0615 | 0.0427 | 0.0767 | 0.0464 | 0.08 | 0.0161 | 0.055 | 0.0387 | 0.0324 | 0.0184 |
| Eisosomes | 0.0009 | 0.0001 | 0.0005 | 0.0014 | 0.0001 | 0.0002 | 0.0005 | 0.0002 | 0.0002 | 0.0002 | 0.0001 | 0.0001 | 0.0003 | 0.0001 | 0.0003 | 0.0001 | 0.0001 | 0.0001 |
| Endoplasmic Reticulum | 0.0118 | 0.0021 | 0.0007 | 0.0012 | 0.0002 | 0.0025 | 0.0079 | 0.0021 | 0.0012 | 0.0013 | 0.0036 | 0.0022 | 0.0048 | 0.0028 | 0.0026 | 0.0005 | 0.0018 | 0.0018 |
| Endosome | 0.0278 | 0.002 | 0.0079 | 0.0189 | 0.0013 | 0.0102 | 0.0438 | 0.0142 | 0.0115 | 0.045 | 0.0458 | 0.0101 | 0.0174 | 0.0051 | 0.0121 | 0.0111 | 0.0281 | 0.0105 |
| Golgi | 0.0122 | 0.0006 | 0.0086 | 0.0097 | 0.0032 | 0.0038 | 0.0149 | 0.003 | 0.0122 | 0.0302 | 0.0167 | 0.0037 | 0.0098 | 0.0014 | 0.0061 | 0.0121 | 0.0113 | 0.0041 |
| Lipid Particles | 0.0148 | 0.0005 | 0.0071 | 0.0388 | 0.0005 | 0.0032 | 0.0178 | 0.0027 | 0.0084 | 0.0221 | 0.0259 | 0.0014 | 0.0094 | 0.0004 | 0.0028 | 0.0231 | 0.0095 | 0.0018 |
| Mitochondria | 0.0038 | 0.0004 | 0.0063 | 0.0031 | 0.0009 | 0.0006 | 0.0059 | 0.0009 | 0.0087 | 0.031 | 0.0519 | 0.0043 | 0.0042 | 0.0121 | 0.0022 | 0.0049 | 0.0444 | 0.0014 |
| None | 0.2392 | 0.2222 | 0.0303 | 0.0698 | 0.0021 | 0.1423 | 0.0955 | 0.086 | 0.0292 | 0.0067 | 0.0296 | 0.0578 | 0.1428 | 0.1989 | 0.1019 | 0.0039 | 0.0625 | 0.1102 |
| Nuclear Periphery | 0.019 | 0.0008 | 0.0004 | 0.0005 | 0.0001 | 0.0066 | 0.0119 | 0.0014 | 0.0004 | 0.0013 | 0.0015 | 0.0015 | 0.0025 | 0.0007 | 0.0007 | 0.0001 | 0.0016 | 0.0004 |
| Nucleolus | 0.0019 | 0.0004 | 0.0005 | 0.0025 | 0.0009 | 0.0004 | 0.0014 | 0.0006 | 0.0005 | 0.0011 | 0.0009 | 0.0002 | 0.0003 | 0.0002 | 0.0009 | 0.0006 | 0.0014 | 0.0001 |
| Nucleus | 0.0069 | 0.0035 | 0.001 | 0.001 | 0.001 | 0.0034 | 0.0105 | 0.0042 | 0.0019 | 0.0019 | 0.0025 | 0.0037 | 0.0019 | 0.0018 | 0.0012 | 0.0005 | 0.0017 | 0.0011 |
| Peroxisomes | 0.0174 | 0.0029 | 0.0226 | 0.0223 | 0.0039 | 0.006 | 0.0205 | 0.0036 | 0.0101 | 0.015 | 0.0232 | 0.0065 | 0.0135 | 0.0011 | 0.0196 | 0.022 | 0.0255 | 0.0032 |
| Punctate Nuclear | 0.0368 | 0.0113 | 0.0027 | 0.0041 | 0.0082 | 0.014 | 0.0189 | 0.0104 | 0.0057 | 0.0032 | 0.0042 | 0.0045 | 0.0077 | 0.0009 | 0.0031 | 0.0008 | 0.0055 | 0.0007 |
| Vacuole | 0.0032 | 0.0014 | 0.0009 | 0.0053 | 0.0005 | 0.0006 | 0.0057 | 0.0042 | 0.0021 | 0.005 | 0.0025 | 0.0013 | 0.0013 | 0.0029 | 0.0016 | 0.0012 | 0.0017 | 0.0017 |
| Vacuole Periphery | 0.0013 | 0.0001 | 0.0002 | 0.0005 | 0.0001 | 0.0004 | 0.0016 | 0.0003 | 0.0003 | 0.0018 | 0.0011 | 0.0003 | 0.0005 | 0.0001 | 0.0002 | 0.0002 | 0.0007 | 0.0004 |
Sequencing Data
| R1 | R2 | |||||||||
|---|---|---|---|---|---|---|---|---|---|---|
| G1 Post-START | S/G2 | Metaphase | Anaphase | Telophase | G1 Post-START | S/G2 | Metaphase | Anaphase | Telophase | |
| Gene Expression | 30.8722 | 34.1499 | 30.9392 | 33.6224 | 31.6762 | 25.7496 | 40.451 | 40.9187 | 32.8168 | 39.7223 |
| Translational Efficiency | 0.3618 | 0.3967 | 0.3587 | 0.3116 | 0.3151 | 0.3289 | 0.327 | 0.2872 | 0.3473 | 0.3057 |
Hit Data
| Dataset | Hit |
|---|---|
| Protein Concentration | ✘ |
| Protein Localization | ✔ |
| Gene Expression | ✘ |
| Translational Efficiency | ✘ |
Endocytosis
| Temp | Actin Patch (Sac6-tdTomato) | Cortical Patch (Sla1-GFP) | Late Endosome (Snf7-GFP) | Vacuole (Vph1-GFP) |
|---|---|---|---|---|
| 37℃ | ||||
| RT |
Cell Cycle Omics
CYCLoPs (Hsl7-GFP)
| Gene / Allele | Actin Patch (Sac6-tdTomato) | Cortical Patch (Sla1-GFP) | Late Endosome (Snf7-GFP) | Vacuole (Sac6-tdTomato) |
|---|
| Gene | Images |
|---|
| Gene | Images |
|---|
Images are not yet available
Images are not yet available